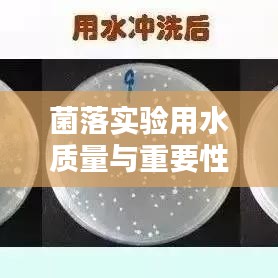

菌落实验是生物学、医学、环境科学等领域中广泛应用的实验方法,用于检测样本中的微生物数量、种类及其生长情况,在菌落实验过程中,水的质量对实验结果具有至关重要的影响,本文将探讨菌落实验用水的特点、质量要求及其在菌落实验中的重要性。
菌落实验用水的特点
1、纯净度高:菌落实验用水必须具有高纯度,以保证实验结果不受水中杂质干扰。
2、无菌性:实验用水需无菌,以避免对样本中微生物生长的干扰。
3、稳定性好:水的化学性质需稳定,以保证实验过程中不会因水质变化影响实验结果。
菌落实验用水的质量要求
1、符合国家相关标准:菌落实验用水需符合国家关于实验室用水的相关标准,如《饮用天然矿泉水》等。
2、微生物指标合格:水中细菌、病毒等微生物含量必须低于检测限。
3、化学物质含量低:水中应尽可能低的含有对微生物生长有影响的化学物质。
4、物理性质稳定:水的pH值、电导率等物理性质需在稳定范围内。
菌落实验用水在菌落实验中的重要性
1、保证实验结果的准确性:高质量的实验用水可以确保菌落实验结果的准确性,避免因水质问题导致实验结果偏差。
2、提高实验的重复性:稳定的实验用水质量有助于实验的重复性,便于对实验结果进行比对和分析。
3、延长实验设备的使用寿命:高质量的实验用水可以保护实验设备,延长其使用寿命。
4、促进微生物的生长与繁殖:合适的实验用水有助于维持微生物的生长环境,促进微生物的繁殖。
菌落实验用水的制备与检测
1、制备:制备菌落实验用水时,需采用多级蒸馏、去离子、反渗透等方法,以确保水质符合要求。
2、检测:定期对实验用水进行检测,确保其符合相关标准,检测项目包括微生物指标、化学物质含量、物理性质等。
菌落实验用水在菌落实验中具有重要意义,高质量的实验用水可以保证实验结果的准确性、提高实验的重复性、延长实验设备的使用寿命,并促进微生物的生长与繁殖,在菌落实验过程中,我们必须重视实验用水的质量与选择,确保实验的顺利进行。
1、实验室应选用符合国家相关标准的实验用水,并定期进行检测,确保其质量符合要求。
2、在进行菌落实验时,应严格按照操作规程进行实验,避免水质污染。
3、实验室可建立用水管理制度,对实验用水的制备、检测、使用等环节进行规范管理。
4、实验室人员应提高水质意识,加强相关培训,提高实验用水的使用效率和质量。
通过以上措施,我们可以确保菌落实验用水的质量,为菌落实验的顺利进行提供有力保障。
转载请注明来自昌宝联护栏,本文标题:《菌落实验用水质量与重要性解析》

冀ICP备19033229号-1
还没有评论,来说两句吧...